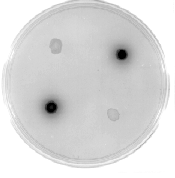

Use of the Neurospora tyrosinase gene as a reporter gene in transformation
experiments.
Gregory Kothe, Maria Deak and Stephen J. Free - Department of Biological
Sciences, SUNY/Buffalo, Buffalo, NY 14260-1300
Reporter gene systems have been developed to allow investigators to
visually identify transformed cells and to follow the transcriptional activity
from promoter regions preceding the reporter genes. These reporter genes
encode protein products which can be easily assayed and which can be strained
for in the transformed cell. The E. coli beta-galactosidase and beta-glucuronidase
genes have been extensively used as reporter genes. The presence of these
proteins can be determined by staining with X-gal and X-gus and the enzyme
levels can be easily quantified by enzymatic assay. Although widely used,
these two systems have some drawbacks for the study of gene expression in
eukaryotic systems. Since the X-gal and X-gus substrates do not efficiently
penetrate eukaryotic cells, the cells must be lysed prior to staining. Being
E. coli genes, the codon usage is quite different from the codon usage within
the eukaryotic cell. The use of the Neurospora tyrosinase gene as a reporter
would overcome these difficulties.
We have developed a vector which allows for the usage of the Neurospora
crassa tyrosinase gene as a reporter system in transformation experiments.
The tyrosinase gene encodes a 75,000 MW protyrosinase peptide which is
subsequently proteolytically cleaved to give an active tyrosinase molecule
(Kupper et al. 1990 Pigment Cell Research 3:207-213). Tyrosinase catalyses
the formation of melanin (an insoluble black pigment) from tyrosine or DOPA.
The tyrosinase gene has the appropriate codon usage, translation start site,
intron splice sites, and polyadenylation/termination site for Neurospora.
Since tyrosine can be translocated into the cells, there is no need to lyse
the cells in order to stain for tyrosinase activity. Furthermore, the levels
of tyrosinase activity can be easily assayed spectrophotometrically. Under
most growth conditions the endogenous tyrosinase gene is repressed and the
level of background tyrosinase activity from the endogenous gene is very low.
We isolated the tyrosinase gene by preparing three oligonucleotides
encoding short regions of the published tyrosinase amino acid sequence (Lerch
1982 Proc. Natl. Acad. Sci. 35:3635-3639). These oligonucleotides were
radioactively labeled and used to identify two cosmids in a cosmid library
(Vollmer and Yanofsky 1986 Proc. Natl. Acad. Sci. 83:4869-4973) which
contained the tyrosinase gene. The tyrosinase gene was subcloned from the
cosmid into the pUC9 vector system and sequenced. The nucleotide sequence
encoded the published amino acid sequence and closely matched the sequence of
the tyrosinase gene which was published during the course of our research
(Kupper et al. 1989 J. Biol. Chem. 264:17250-17258). We found that an
EcoRI/XhoI fragment contained all of the coding sequences as well as 5' and 3'
sequences (including the polyA addition site). This region was subcloned into
the pBluescript vector to generate the plasmid pTYR1.
To prepare a reporter gene construct, we wanted to remove the 5'
sequences up to a point near the start of translation site while retaining the
coding and 3' sequences. Unwanted 5' sequences were removed from the pTYR1 by
Bal31 digestion. pTYR1 was linearized by digestion with the EcoRI restriction
endonuclease and subjected to digestion with Bal31 exonuclease. Following the
Bal31 digestion, EcoRI linkers were added to the digested ends. The DNA was
then subjected to digestion with EcoRI and XhoI restriction endonucleases.
The fragment containing the tyrosinase gene was purified by electrophoresis in
an agarose gel and ligated into pBluescript vector which had been digested
with EcoRI and XhoI. Sequencing of several plasmids allowed us to identify
those which would be of value for use as reporter gene vectors. One of the
plasmids, pTYR103, was chosen as an expression vector. pTYR103 contains 18
nucleotides of tyrosinase sequence upstream of the AUG start of translation
codon. pTYR103 can be used in preparing constructs in which promoter regions
are inserted upstream of the tyrosinase sequences. pTYR103 contains unique
restriction sites for EcoRI and XbaI upstream of the tyrosinase gene. A map
of pTYR103 is given as Figure 1. pTYR103 has been deposited in the Fungal
Genetics Stock Center.
To test pTYR103 as a reporter system, we inserted the regulatory region
from the Neurospora grg-1 (ccg-1) gene upstream of the tyrosinase sequences.
The resultant expression plasmid, pGRG-1/TYR103 was used to transform
Neurospora cells. The cells used for the transformation were aro-9;qa-2
mutants and the cells were cotransformed with the qa-2-containing pRAL-1
(Akins and Lambowitz 1986 Mol. Cell. Biol. 5:2272-2278) and the pGRG-1/TYR103
plasmids. After five rounds of conidial isolation, the transformants were
spotted onto sorbose plates and allowed to grow for 2 to 3 days. One ml of a
10 mM tyrosine suspension was added to the plates. We found that 42 of 66
transformants from the cotransformation experiment stained black within a few
hours while none of the transformants from a control transformation
(transformation with pRAL-1 vector alone) stained. Figure 2 shows four
transformants growing on sorbose medium and stained for tyrosinase activity.
The upper left and lower right quadrants contain control transformants (pRAL-1
transformant). The upper right and lower left quadrants have pGRG-1/TYR103
cotransformants.
The protyrosinase encoded by the tyrosinase gene is an enzymatically
inactive precursor molecule which must have the carboxyl terminus removed by
proteolytic processing to become an active enzyme. Kupper et al. (1990
Pigment Cell Research 3:207-213) have recently shown that when the endogenous
tyrosinase gene is induced in mycelia, the protyrosinase produced is
inefficiently processed and most of the molecules remain in the inactive
protyrosinase form. Upon disruption of the cell the protyrosinase is
proteolytically processed to the active form. The inefficiency of
intracellular proteolytic processing in mycelia was demonstrated by Western
blot analysis and by the increase in tyrosinase activity seen as a function of
incubation of the extract at 25řC prior to assaying for tyrosinase activity.
We found the same phenomenon when looking at the protyrosinase produced from
our expression system. However, we found that the levels of tyrosinase
activity (processed protyrosinase) were adequate to allow for the convenient
staining of transformed cells (Figure 2). The level
of tyrosinase present in the transformants can be
easily determined by an enzymatic assay. When
quantitating the levels of tyrosinase activity in
transformants, we suggest that the cellular extracts
are dialyzed against 50 mM sodium phosphate buffer,
pH 6, for at least two hours at room temperature to
remove endogenous substrate and to allow for the
proteolytic processing of the protyrosinase
molecules. We have also found that we can follow
the production of the tyrosinase mRNA in
transformants by Northern blot.

Figure 1. A restriction endonuclease map of
pTYR103. pBluescriptII SK- vector and tyrosinase
sequences are shown in the striped and unstriped
portions of the map respectively. The sites for
various endonucleases are shown. pTYR103 has unique
cloning sites for EcoRI and XbaI into which
regulatory sequences can be inserted upstream of the
tyrosinase gene. Below the map, the nucleotide
sequence at the 5' end of the tyr gene in pTYR103 is
shown. The BamHI, SmaI, PstI and EcoRI sites are
from the pBluescript vector. The initiation of
translation codon and subsequent codons are denoted.
 Figure 2. Staining of transformants containing pTYR103 plasmid sequences. pGRG-
1/TYR103 transformants (in upper right and lower left quadrants) and control
transformants (transformed with pRAL1) were placed on a sorbose plate and allowed to
grow for 2 days. The transformants were stained for tyrosinase activity by adding 1 ml of
10 mM tyrosine suspension to the plate. The plate was photographed 4 hours after
adding the tyrosine.
Figure 2. Staining of transformants containing pTYR103 plasmid sequences. pGRG-
1/TYR103 transformants (in upper right and lower left quadrants) and control
transformants (transformed with pRAL1) were placed on a sorbose plate and allowed to
grow for 2 days. The transformants were stained for tyrosinase activity by adding 1 ml of
10 mM tyrosine suspension to the plate. The plate was photographed 4 hours after
adding the tyrosine.
Figure 2. Staining of transformants containing pTYR103 plasmid sequences. pGRG-
1/TYR103 transformants (in upper right and lower left quadrants) and control
transformants (transformed with pRAL1) were placed on a sorbose plate and allowed to
grow for 2 days. The transformants were stained for tyrosinase activity by adding 1 ml of
10 mM tyrosine suspension to the plate. The plate was photographed 4 hours after
adding the tyrosine.
Figure 2. Staining of transformants containing pTYR103 plasmid sequences. pGRG-
1/TYR103 transformants (in upper right and lower left quadrants) and control
transformants (transformed with pRAL1) were placed on a sorbose plate and allowed to
grow for 2 days. The transformants were stained for tyrosinase activity by adding 1 ml of
10 mM tyrosine suspension to the plate. The plate was photographed 4 hours after
adding the tyrosine.